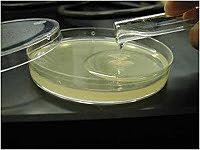
Hidrocoloide reversible (material indirecto)

-
Se introdujo por primera vez como materiales restauradores.
La cerámica dental son materiales que forman parte de los sistemas diseñados con el propósito de producir prótesis dentales que a su vez se utilizan para reemplazar las estructuras dentales faltantes o dañadas. -
Se introdujo el feldespato como el flujo en las porcelanas chinas.
-
Primer uso de la porcelana para hacer prótesis completa.
-
La lámina de oro fue introducida por primera vez en Estados Unidos por Robert Woofendale en 1795 y fue uno de los primeros materiales disponibles para la restauración de dientes. Arthur descubrió la lámina de oro cohesiva en 1855. Este fue el mayor avance de la odontología.
-
August Taveau de París combinó plata y mercurio para formar una pasta de plata en 1826 y dio como resultado el comienzo de la amalgama dental, un desarrollo sobresaliente en el campo de la odontología operativa.
-
Dr. D. Philbrook en 1897 describió un método de yeso para la restauración de dientes posteriores.
-
Alphons Poller introdujo el hidrocoloide reversible en odontología para fabricar reproducciones en yeso
-
Durante la Segunda Guerra Mundial, los hidrocoloides irreversibles (alginatos) se inventaron para la profesión dental.
-
Se inventaron las resinas de metacrilato de metilo de relleno directo para superar los problemas de los silicatos ya que el silicato fue el primer material del color de los dientes utilizado en odontología estética. Junto con la ventaja de una alta liberación de fluoruro, el cemento de silicato tenía desventajas de su solubilidad, potencial de irritación de la pulpa y desecación.
-
En 1953, los materiales de impresión de polisulfuro llegaron a la odontología quirúrgica y prostodóntica. Luego, los descubrimientos de los poliéteres, la silicona de condensación y la silicona de adición ofrecieron materiales más estables y menos desordenados a la odontología.
-
Un gran descubrimiento del Dr. Michael Buonocore del ácido fosfórico para aumentar la unión mecánica de la resina al esmalte en 1955 abrió nuevas puertas en el mundo de las resinas adhesivas y la odontología cosmética.
-
Las coronas de porcelana mostraron buenas propiedades estéticas, pero baja resistencia a la flexión, lo que resultó en una mayor incidencia de fallas clínicas en comparación con el sistema cerámico metálico.
McLean y Hughes utilizaron un núcleo de matriz de vidrio compuesto de 40 a 50 wt% Al2O3 para fabricar la primera corona de chaqueta de porcelana cerámica (cerámica de núcleo reforzada con alúmina). -
GIC fue desarrollado en 1968 y fue descrito y nombrado por primera vez por Wilson y Kent en 1971. El GIC ha sido desarrollado a partir del cemento de silicato y policarboxilato y por lo tanto actúa como un reemplazo potencial del cemento de silicato. Debido a su adhesión al esmalte y a la dentina y a la liberación de flúor con efecto anticariógeno, ganó gran popularidad en la profesión dental.
Looking for a timeline maker?
Create timelines for projects, roadmaps, history, lessons, legal cases, and stories with Timetoast. Timetoast is a timeline maker for work, school, research, and stories.